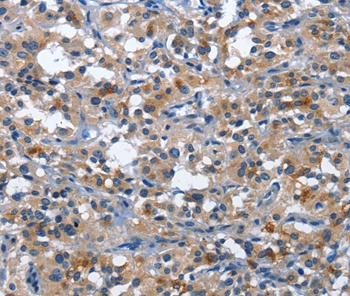

-
分类: 科研抗体货号: P42820别名: RIM; COM1; CTIP; JWDS; SAE2; SCKL2应用: IHC反应种属: Human
-
分类: 科研抗体货号: P42799别名: CDG1G; ECM39; hALG12; PP14673应用: WB,IHC反应种属: Human
-
分类: 科研抗体货号: P42819别名: PLA2G4; cPLA2-alpha应用: WB,IHC反应种属: Human
-
分类: 科研抗体货号: P42829别名: 3'-Tab1; MAP3K7IP1应用: WB,IHC反应种属: Human
-
分类: 科研抗体货号: P42817别名: NB1; PRV1; HNA2A; PRV-1; HNA-2a; NB1 GP应用: IHC反应种属: Human
-
分类: 科研抗体货号: P42828别名: KV4.3; SCA19; SCA22; KCND3L; KCND3S; KSHIVB应用: WB反应种属: Human,Mouse
-
分类: 科研抗体货号: P42815别名: ILA; 4-1BB; CD137; CDw137应用: IHC反应种属: Human
-
分类: 科研抗体货号: P42827别名: JMJD2D应用: WB,IHC反应种属: Human
-
分类: 科研抗体货号: P42846别名: AP-1应用: WB,IHC反应种属: Human
-
分类: 科研抗体货号: P42826别名: CRF2X; CRF2-10; CRF2-S1; IL-22BP; IL-22RA2; ZCYTOR16; IL-22R-alpha-2应用: WB反应种属: Human

鄂公网安备42018502007531号
鄂公网安备42018502007531号

